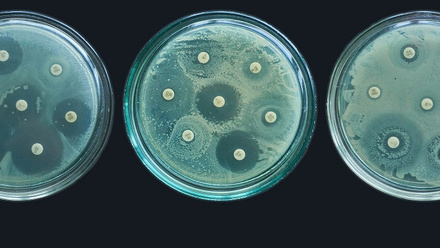
DS AMR image July 2023 resize.jpg

Antimicrobial resistance at International Pathology Day
Antimicrobial resistance (AMR) is one of the most pressing global health challenges the world faces today. The prediction is that, unless we take urgent action, 10 million people each year could die from the effects of AMR by 2050.
AMR affects everyone, everywhere, regardless of income status or nationality. From the misuse and overuse of antibiotics to lack of clean water and inadequate healthcare infrastructure, the causes of AMR are complicated and critical.
On Wednesday 6 November, from 9:45 for a 10:00 GMT start, our virtual conference for International Pathology Day will focus on the theme ‘The rise of global antimicrobial resistance’ and explore these issues in partnership with our sponsor, the British Society for Haematology.
We are honoured to welcome Professor Dame Sally Davies, the UK’s Special Envoy on AMR, who will open the conference in conversation with College President, Dr Bernie Croal and Vice President for Communications, Dr Noha El Sakka.
This will lead on to additional presentations from speakers from across the globe. Visit our event page to discover more about our speakers.
Our signature roundtable discussion
A discussion on ‘Global perspectives on AMR’ will take place in the afternoon. Inspired by our 6-part free global AMR webinar series that took place this summer, our panel of experts below will offer their insights on AMR.
They will explore the challenges and opportunities in different regions and highlight the similarities in our experiences and the priorities for addressing this issue. The panellists at the event will be:
- Chair: Dr Bernie Croal, President, The Royal College of Pathologists, UK
- Panellist: Dr David Jenkins, Consultant in Medical Microbiology and Virology and Lead Infection Control Doctor, University Hospitals of Leicester NHS Trust, UK
- Panellist: Dr Margaret Ip, Hong Kong
- Panellist: Professor Samuel Taiwo, Nigeria
- Panellist: Professor Daniel Thirion, Full Clinical Professor, Pharmacist, Université de Montréal, Montreal and McGill University Health Centre, Canada
Digital poster competition
The theme of this year’s competition is ‘Conquering superbugs: innovations in combating AMR’. Entries are invited from individuals and teams until the closing date on Wednesday 23 October at midnight BST. Find out how to enter, the terms and conditions and the cash prizes to be won from our event page.Lunchtime activities
The College has significantly increased its efforts around AMR and there will be a presentation highlighting the work around this.
Secure your place and be a part of this vital conversation – register now. Together, we can make a difference in the global fight against AMR.
The International team
Read next